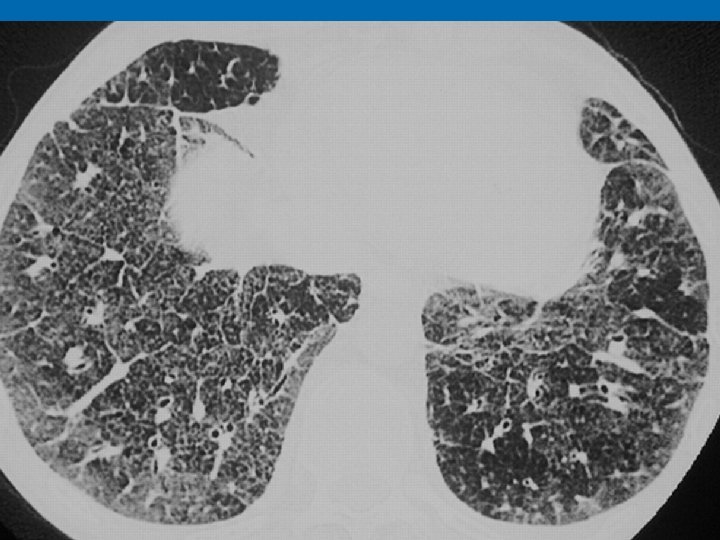

1630ef8c4bde38a6e6fa7f821dd63f3a.ppt
- Количество слайдов: 97
 SİSTEMİK SARKOİDOZ PROF. DR. HALİL YANARDAĞ
SİSTEMİK SARKOİDOZ PROF. DR. HALİL YANARDAĞ
 GENEL BİLGİLER Ø Sarkoidoz, nedeni bilinmeyen, çoğunlukla genç erişkinlerde görülen, etkilenen organlarda nonkazeifiye, epiteloid granülomlarla karekterize; akciğerler başta olmak üzere, deri, göz, miyokard, SSS, eklem ve kemikleri tutan; Ø diğer granülomatöz hastalıkların dışlanmasıyla tanı konan, multisistemik granülomatöz bir hastalıktır.
GENEL BİLGİLER Ø Sarkoidoz, nedeni bilinmeyen, çoğunlukla genç erişkinlerde görülen, etkilenen organlarda nonkazeifiye, epiteloid granülomlarla karekterize; akciğerler başta olmak üzere, deri, göz, miyokard, SSS, eklem ve kemikleri tutan; Ø diğer granülomatöz hastalıkların dışlanmasıyla tanı konan, multisistemik granülomatöz bir hastalıktır.

 EPİDEMİYOLOJİ Ø Ülkelere, farklı coğrafi bölgelere ve ırklara göre farklı prevalans gösterir Ø Afrikalılarda insidans yüksektir Ø Avrupada nedeni bilinmeyen interstisyel akciğer hastalıkları arasında ilk sırada yer alır Ø 20 -40 yaş daha sık görülür Ø İnsidansı kış ve ilkbaharda pik yapar
EPİDEMİYOLOJİ Ø Ülkelere, farklı coğrafi bölgelere ve ırklara göre farklı prevalans gösterir Ø Afrikalılarda insidans yüksektir Ø Avrupada nedeni bilinmeyen interstisyel akciğer hastalıkları arasında ilk sırada yer alır Ø 20 -40 yaş daha sık görülür Ø İnsidansı kış ve ilkbaharda pik yapar
 ETİYOLOJİ Ø Hastalık 100 yıl önce tanımlanmış olmasına rağmen etiyoloji hala kesin olarak bilinmemektedir Ø Genetik yatkınlık? Ø Hastaların %5 -16 sında ailesel yatkınlık – HLA-1, -B 8, B 13, -DR 3 ve –B 27 ile ilişki görülmüştür. Ø Zenci popülasyonda daha sık Ø Bir çok ajanın granülomatöz reaksiyonu tetiklemesi?
ETİYOLOJİ Ø Hastalık 100 yıl önce tanımlanmış olmasına rağmen etiyoloji hala kesin olarak bilinmemektedir Ø Genetik yatkınlık? Ø Hastaların %5 -16 sında ailesel yatkınlık – HLA-1, -B 8, B 13, -DR 3 ve –B 27 ile ilişki görülmüştür. Ø Zenci popülasyonda daha sık Ø Bir çok ajanın granülomatöz reaksiyonu tetiklemesi?
 Bağışıklık sistem bozuklukları: Ø BAL ve tutulan dokularda CD 4/CD 8 oranı artar. Ø CD 4/CD 8 >3. 5(sensitivite %50 -60, spesifisite %90) Ø Periferik kanda lenfopeni Ø T lenfositler azalır ve PPD test negatif. humoral bağışıklık sağlam kalır. Lab: 24 saatlık idrarda ca artmış, %60’ında kanda ACE düzeyi artmış Ø Karaciğer tutulumunda alkalı fosfataz artar
Bağışıklık sistem bozuklukları: Ø BAL ve tutulan dokularda CD 4/CD 8 oranı artar. Ø CD 4/CD 8 >3. 5(sensitivite %50 -60, spesifisite %90) Ø Periferik kanda lenfopeni Ø T lenfositler azalır ve PPD test negatif. humoral bağışıklık sağlam kalır. Lab: 24 saatlık idrarda ca artmış, %60’ında kanda ACE düzeyi artmış Ø Karaciğer tutulumunda alkalı fosfataz artar
 KLİNİK 23 vaka asemptomatik En sık akciğer tutulumu Ekstrapulmoner tutulum sıklık sırası: 1. Cilt 2. Periferik lenf bezi 3. Karaciğer 4. Göz 5. Kalp 6. Tükrük-gözyaşıbezi 7. Kas, sinir, beyin 8. Kemik iliği
KLİNİK 23 vaka asemptomatik En sık akciğer tutulumu Ekstrapulmoner tutulum sıklık sırası: 1. Cilt 2. Periferik lenf bezi 3. Karaciğer 4. Göz 5. Kalp 6. Tükrük-gözyaşıbezi 7. Kas, sinir, beyin 8. Kemik iliği
 Ø Klinik prezantasyonlar; Ø Akut Ø Subakut Ø Kronik
Ø Klinik prezantasyonlar; Ø Akut Ø Subakut Ø Kronik
 AKUT FORM LÖFGREN SENDROMU Ø Eritema nodosum Ø Poliartrit Ø Bilateral hiler lenfadenopati Ø Ateş Ø Halsizlik Ø Üveit
AKUT FORM LÖFGREN SENDROMU Ø Eritema nodosum Ø Poliartrit Ø Bilateral hiler lenfadenopati Ø Ateş Ø Halsizlik Ø Üveit
 SUBAKUT FORM Ø Kliniği akut formdan farklılık gösteren Ø Semptomları 2 yıldan kısa olan formlardır.
SUBAKUT FORM Ø Kliniği akut formdan farklılık gösteren Ø Semptomları 2 yıldan kısa olan formlardır.
 KRONİK FORM Ø 2 yıldan eski olgular Ø Fibrokistik akciğer hastalığına kadar uzanan geniş bir spektrum Ø Ekstrapulmoner sarkoidoz
KRONİK FORM Ø 2 yıldan eski olgular Ø Fibrokistik akciğer hastalığına kadar uzanan geniş bir spektrum Ø Ekstrapulmoner sarkoidoz
 YAKINMALAR Ø Ateş, yorgunluk, kilo kaybı, zaman gece terlemesi gibi nonspesifik bulgular Ø %90 dan fazla olguda akciğer tutulumu, dispne, kuru öksürük, göğüste sıkışma hissi, fibrokistik tutulum olan akciğerde kronik balgam çıkartma ve hemoptizi
YAKINMALAR Ø Ateş, yorgunluk, kilo kaybı, zaman gece terlemesi gibi nonspesifik bulgular Ø %90 dan fazla olguda akciğer tutulumu, dispne, kuru öksürük, göğüste sıkışma hissi, fibrokistik tutulum olan akciğerde kronik balgam çıkartma ve hemoptizi
 FİZİK MUAYENE Ø İleri evrelerde akciğerlerde raller Ø Endobronşial tutulum ve bronş hiperreaktivitsinde ronküs ve wheezing duyulur Ø Nadiren pulmoner hipertansiyon görülür
FİZİK MUAYENE Ø İleri evrelerde akciğerlerde raller Ø Endobronşial tutulum ve bronş hiperreaktivitsinde ronküs ve wheezing duyulur Ø Nadiren pulmoner hipertansiyon görülür
 TANISAL YÖNTEMLER PA akciğer grafisi Ø HRCT Ø Akciğer fonksiyon testleri Ø Bronkoskopi Ø Bronkoalveoler lavaj Ø Mediastinoskopi Ø Serum ACE miktarı Ø Kveim-Siltzbach deri testi Ø Biopsi Ø
TANISAL YÖNTEMLER PA akciğer grafisi Ø HRCT Ø Akciğer fonksiyon testleri Ø Bronkoskopi Ø Bronkoalveoler lavaj Ø Mediastinoskopi Ø Serum ACE miktarı Ø Kveim-Siltzbach deri testi Ø Biopsi Ø
 Sarkoidozda organ tutulumu Akciğer %90 Ø Deri %10 -25 Ø Göz %20 Ø Tükrük bezi %5 Ø Periferik LAM %30 Ø Sinir sistemi %5 Ø Kalp %20 -30 Ø Karaciğer %50 -90 Ø Dalak %35 -75 Ø Böbrek %20 Ø Ürogenital sistem %10 Ø Kemik %5 Ø Eklem-kas %30 Ø Endokrin %5 Ø
Sarkoidozda organ tutulumu Akciğer %90 Ø Deri %10 -25 Ø Göz %20 Ø Tükrük bezi %5 Ø Periferik LAM %30 Ø Sinir sistemi %5 Ø Kalp %20 -30 Ø Karaciğer %50 -90 Ø Dalak %35 -75 Ø Böbrek %20 Ø Ürogenital sistem %10 Ø Kemik %5 Ø Eklem-kas %30 Ø Endokrin %5 Ø
 PA AKCİĞER GRAFİSİ Ø Grafiye göre evreleme yapılır: Evre 0: normal Ø Evre 1: bilateral hiler, mediastinal veya paratrakeal LAP Ø Evre 2: evre 1 + parankimal infiltrasyonlar Ø Evre 3: LAP ın eşlik etmediği diffuz pulmoner parankimal infiltrasyonlar Ø Evre 4: LAP ın eşlik etmediği fibro-kistik interstisyel akciğer hastalığı Ø
PA AKCİĞER GRAFİSİ Ø Grafiye göre evreleme yapılır: Evre 0: normal Ø Evre 1: bilateral hiler, mediastinal veya paratrakeal LAP Ø Evre 2: evre 1 + parankimal infiltrasyonlar Ø Evre 3: LAP ın eşlik etmediği diffuz pulmoner parankimal infiltrasyonlar Ø Evre 4: LAP ın eşlik etmediği fibro-kistik interstisyel akciğer hastalığı Ø

 Stage I. Posteroanterior (PA) chest radiograph shows bilateral hilar and mediastinal adenopathy without parenchymal disease.
Stage I. Posteroanterior (PA) chest radiograph shows bilateral hilar and mediastinal adenopathy without parenchymal disease.

 2 SENE SONRA
2 SENE SONRA
 Stage II. PA chest radiograph demonstrates hilar and mediastinal adenopathy with fine nodular interstitial opacities.
Stage II. PA chest radiograph demonstrates hilar and mediastinal adenopathy with fine nodular interstitial opacities.

 Stage III. PA chest radiograph depicts diffuse bilateral reticulonodular opacities without lymphadenopathy.
Stage III. PA chest radiograph depicts diffuse bilateral reticulonodular opacities without lymphadenopathy.
 Stage IV. PA chest radiograph shows fibrosis and upper lobe cystic changes and volume loss.
Stage IV. PA chest radiograph shows fibrosis and upper lobe cystic changes and volume loss.
 EVRE 4
EVRE 4
Ø ORGAN TUTULUMLARI Ø Üst solunum yolları • • • 5 -20% Nazal granulomlar. Laringeal tutulum 5%. Ø Akciğer • >90% • dispne, kuru öksürük, göğüs ağrısı (alkol alımı sonrası yoğunlaşır), hemoptizi
Ø ORGAN TUTULUMLARI Ø Üst solunum yolları • • • 5 -20% Nazal granulomlar. Laringeal tutulum 5%. Ø Akciğer • >90% • dispne, kuru öksürük, göğüs ağrısı (alkol alımı sonrası yoğunlaşır), hemoptizi
 Ø Kalp • İletim bozukluğu; MI; perikardial hastalık; ani ölüm (27% otopside); cor pulmonale. Ø Karaciğer • Hepatomegali (biopsi ve otopside granuloma 63 -87%) • Genelde asemptomatik Ø Dalak • Splenomegali; genelde sessizdir (50% otopside bulunur) Ø Böbrekler • Hiperkalsemi / hiperkalsiüri; renal parankimin granulomatöz infiltrasyonu, granulomlara sekonder olarak gelişen glomerular hastalık veya renal arterit Ø Salgı bezleri • Parotido-megali; subklinik 50% (fakat genellikle sadece hilar adenopati ile birlikte); sarkoidal granul; dil, tonsiller.
Ø Kalp • İletim bozukluğu; MI; perikardial hastalık; ani ölüm (27% otopside); cor pulmonale. Ø Karaciğer • Hepatomegali (biopsi ve otopside granuloma 63 -87%) • Genelde asemptomatik Ø Dalak • Splenomegali; genelde sessizdir (50% otopside bulunur) Ø Böbrekler • Hiperkalsemi / hiperkalsiüri; renal parankimin granulomatöz infiltrasyonu, granulomlara sekonder olarak gelişen glomerular hastalık veya renal arterit Ø Salgı bezleri • Parotido-megali; subklinik 50% (fakat genellikle sadece hilar adenopati ile birlikte); sarkoidal granul; dil, tonsiller.
 Ø Romatolojik • Eklem tutulumu; 2 form – akut and kronik (<6 ay). • İlerleyen yıllarda diğer bulgulardan daha belirginleşebilir. • Dizler > ayak bilekleri > dirsekler > el bilekleri > elin küçük eklemleri (tipik olarak 2 -6 eklem). • Periartiküler şişme > efüzyon • Sinovyal sıvı genelde non-inflamatuardır. • Tenosinovitis ve topuk ağrısı meydana gelebilir.
Ø Romatolojik • Eklem tutulumu; 2 form – akut and kronik (<6 ay). • İlerleyen yıllarda diğer bulgulardan daha belirginleşebilir. • Dizler > ayak bilekleri > dirsekler > el bilekleri > elin küçük eklemleri (tipik olarak 2 -6 eklem). • Periartiküler şişme > efüzyon • Sinovyal sıvı genelde non-inflamatuardır. • Tenosinovitis ve topuk ağrısı meydana gelebilir.
 Ø Muskuler • • • Progresif proximal kas güçsüzlüğü; myopatik EMG, artmış Cp. K Ø Endokrin • • • Pituitar & hipothalamus – diabet, hipertiroidizm. Prolaktin yüksekliği. Intermitan hiperkalsemi – 17 -19%.
Ø Muskuler • • • Progresif proximal kas güçsüzlüğü; myopatik EMG, artmış Cp. K Ø Endokrin • • • Pituitar & hipothalamus – diabet, hipertiroidizm. Prolaktin yüksekliği. Intermitan hiperkalsemi – 17 -19%.
 Ø Laboratuar: • Anemi 5% • Lökopeni – kemik iliği tutulumunun gösterir – 28% • Eozinofili 24 -34% • ESR 66%; Haptoglobin yüksekliği 40%. • Hiperkalsemi (artmış intestinal Ca absorbsiyonu; (3 H)1, 25(OH)2 D 3 üretimine bağlı 19% • ACE 60% ( DM, alkolik karaciğer hastalığı, Hep C, tuberkuloz, lepra, lenfoma, hipertiroidizm, Whipple’s, silikozis, histoplasmozis, berylliosis, serum lizozim, B 2 -mikroglobulinleri.
Ø Laboratuar: • Anemi 5% • Lökopeni – kemik iliği tutulumunun gösterir – 28% • Eozinofili 24 -34% • ESR 66%; Haptoglobin yüksekliği 40%. • Hiperkalsemi (artmış intestinal Ca absorbsiyonu; (3 H)1, 25(OH)2 D 3 üretimine bağlı 19% • ACE 60% ( DM, alkolik karaciğer hastalığı, Hep C, tuberkuloz, lepra, lenfoma, hipertiroidizm, Whipple’s, silikozis, histoplasmozis, berylliosis, serum lizozim, B 2 -mikroglobulinleri.
 Laboratuar • Tüberkülin – Kutanoz anerji 66% • CD 4: CD 8 – normal 1. 8: 1; düşük-aktiviteli sarkoid 1. 4: 1; yüksekyoğunluklu alveolit 0. 8: 1. • Hipergammaglobulinemi 50% • Bronkoalveolar lavaj (BAL) – sıvı lenfosit sayısı >7% lenfositler; CD 4/CD 8 >3. 5. • 67 Gallium’da panda veya lambda işaretleri (parotid & lakrimal bezlerden granuloma gallium tutulumu [panda] and bilateral hilar lenf nodu tutulumu [lambda]). • Kveim-Siltzbach testi (90% hilar adenopati eşlik ediyorsa).
Laboratuar • Tüberkülin – Kutanoz anerji 66% • CD 4: CD 8 – normal 1. 8: 1; düşük-aktiviteli sarkoid 1. 4: 1; yüksekyoğunluklu alveolit 0. 8: 1. • Hipergammaglobulinemi 50% • Bronkoalveolar lavaj (BAL) – sıvı lenfosit sayısı >7% lenfositler; CD 4/CD 8 >3. 5. • 67 Gallium’da panda veya lambda işaretleri (parotid & lakrimal bezlerden granuloma gallium tutulumu [panda] and bilateral hilar lenf nodu tutulumu [lambda]). • Kveim-Siltzbach testi (90% hilar adenopati eşlik ediyorsa).
 DEĞİŞİK RADYOLOJİK GÖRÜNÜMLER RETİKÜLONODÜLER PATERN
DEĞİŞİK RADYOLOJİK GÖRÜNÜMLER RETİKÜLONODÜLER PATERN
 ASİNER PATERN
ASİNER PATERN
 PNÖMONİK GÖRÜNÜM
PNÖMONİK GÖRÜNÜM
 ALVEOLER SARKOİDOZ
ALVEOLER SARKOİDOZ
 KAVİTER SARKOİDOZ
KAVİTER SARKOİDOZ
 HRCT Ø Akciğer grafisine göre daha duyarlı Ø Paratrakeal, pretrakeal, paraaortik ve subkarinal adenopatilerde tespit edilebilir
HRCT Ø Akciğer grafisine göre daha duyarlı Ø Paratrakeal, pretrakeal, paraaortik ve subkarinal adenopatilerde tespit edilebilir







 AKCİĞER FONKSİYON TESTLERİ Ø Grafideki evrelerle yakın ilişki Ø Evre-1 %80 normal Ø %30 -50 hastada obstrüktif tipte ventilasyon azalması Ø Pulmoner infiltrasyon varsa, %40 -70 FVC, FEV-1’de düşmeyle birlikte restriktif tipte ventilasyon azalması
AKCİĞER FONKSİYON TESTLERİ Ø Grafideki evrelerle yakın ilişki Ø Evre-1 %80 normal Ø %30 -50 hastada obstrüktif tipte ventilasyon azalması Ø Pulmoner infiltrasyon varsa, %40 -70 FVC, FEV-1’de düşmeyle birlikte restriktif tipte ventilasyon azalması
 BRONKOSKOPİ Ø Akciğer infiltrasyonu görülen hastalara Ø Transbronşiyal Ø En az 4 -6 örnek Ø BAL avantajı
BRONKOSKOPİ Ø Akciğer infiltrasyonu görülen hastalara Ø Transbronşiyal Ø En az 4 -6 örnek Ø BAL avantajı
 Ø Deri bulgusu olmayanlarda bronkoskopi ile transbronşiyal lenf nodu biopsisi yapılmalıdır. Ø Bronkoskopi sırasında BAL(Bronkoalveoler lavaj) ile lökosit değişimleri saptanabilir. CD 4/CD 8 oranı >3, 5 ise sarkoidoz göstergesidir.
Ø Deri bulgusu olmayanlarda bronkoskopi ile transbronşiyal lenf nodu biopsisi yapılmalıdır. Ø Bronkoskopi sırasında BAL(Bronkoalveoler lavaj) ile lökosit değişimleri saptanabilir. CD 4/CD 8 oranı >3, 5 ise sarkoidoz göstergesidir.
 BRONKOALVEOLAR LAVAJ Ø CD 4/CD 8 oranı yüksek(%90) Ø Akciğer sarkoidozu aktivitesiyle ilişkili ancak tanı için yeterli değil
BRONKOALVEOLAR LAVAJ Ø CD 4/CD 8 oranı yüksek(%90) Ø Akciğer sarkoidozu aktivitesiyle ilişkili ancak tanı için yeterli değil
 MEDİASTİNOSKOPİ Ø Lenfoma ve diğer intratorasik maligniteleri dışlamada yararlı Ø Radyografide olağan dışı asimetrik veya aşırı büyük hiler LAP görülüyorsa, bronkoskopik biyopsi pozitif olsa bile mediastinoskopi endikasyonu var
MEDİASTİNOSKOPİ Ø Lenfoma ve diğer intratorasik maligniteleri dışlamada yararlı Ø Radyografide olağan dışı asimetrik veya aşırı büyük hiler LAP görülüyorsa, bronkoskopik biyopsi pozitif olsa bile mediastinoskopi endikasyonu var
 SERUM ANJİOTENSİN KONVERTİNG ENZİM (SACE) Ø Normalde pulmoner kapiller endotelinde, AT-1’İ AT-2’ye çevirir Ø Sarkoidozda ACE’nin önemli bir kısmı granülomlarda üretilir Ø ACE granulom oluşumunda modülatör? Granülomlarda AT-2 üretimi? Ø Steroidle tedavi edilmemiş aktif sarkoidozlu hastaların %40 -90’ında SACE yüksek
SERUM ANJİOTENSİN KONVERTİNG ENZİM (SACE) Ø Normalde pulmoner kapiller endotelinde, AT-1’İ AT-2’ye çevirir Ø Sarkoidozda ACE’nin önemli bir kısmı granülomlarda üretilir Ø ACE granulom oluşumunda modülatör? Granülomlarda AT-2 üretimi? Ø Steroidle tedavi edilmemiş aktif sarkoidozlu hastaların %40 -90’ında SACE yüksek
 SACE Ø Sarkoid granüloma, BAL sıvısı, gözyaşı ve serebrospinal sıvıda tespit edilmiş Ø Kronik berilyozis, silikozis, lepra, Hodgkin hastalığı, mantar, mikobakteriyel hastalıklar gibi granülomatöz hastalıklar, Gaucher hastalığı, hipertiroidi, karaciğer sirozu ve diabetes mellitusta da yüksek Ø Tanıya sınırlı katkı sağlar Ø Sarkoidoz regresyonunda ve steroid tedavisinde düşer
SACE Ø Sarkoid granüloma, BAL sıvısı, gözyaşı ve serebrospinal sıvıda tespit edilmiş Ø Kronik berilyozis, silikozis, lepra, Hodgkin hastalığı, mantar, mikobakteriyel hastalıklar gibi granülomatöz hastalıklar, Gaucher hastalığı, hipertiroidi, karaciğer sirozu ve diabetes mellitusta da yüksek Ø Tanıya sınırlı katkı sağlar Ø Sarkoidoz regresyonunda ve steroid tedavisinde düşer
 BİYOPSİ Ø Yoğun, nonkazeifiye granulom Ø Merkezden çevreye doğru yayılan, soluk nukleuslu epiteloid hücreler, az multinukleer dev hücre, sınırlı sayıda lenfositik infiltrasyon Ø Schaumann ve asteroid inklüzyon cisimcikleri
BİYOPSİ Ø Yoğun, nonkazeifiye granulom Ø Merkezden çevreye doğru yayılan, soluk nukleuslu epiteloid hücreler, az multinukleer dev hücre, sınırlı sayıda lenfositik infiltrasyon Ø Schaumann ve asteroid inklüzyon cisimcikleri
 Sarkoidozda görülen non-kazeifiye granulomlarla karakterize histolojik görünüm
Sarkoidozda görülen non-kazeifiye granulomlarla karakterize histolojik görünüm
 Sarkoid granülomlar
Sarkoid granülomlar
 Sarkoidoz – Deri bulguları Genellikle hastalığın ilk başlarında görülür. • Hastalığın derecesiyle korele değildir. • Deri lezyonlarının görülmediği durumlarda lenfadenopati & hepatosplenomegali görülmesi daha olasıdır. • • Spesifik (granulom içeren lezyonlar) • Non-spesifik (granuloma içermeyen, reaktif durumlar).
Sarkoidoz – Deri bulguları Genellikle hastalığın ilk başlarında görülür. • Hastalığın derecesiyle korele değildir. • Deri lezyonlarının görülmediği durumlarda lenfadenopati & hepatosplenomegali görülmesi daha olasıdır. • • Spesifik (granulom içeren lezyonlar) • Non-spesifik (granuloma içermeyen, reaktif durumlar).
 Spesifik Deri Lezyonları: Makulopapular sarkoid Ø Noduler sarkoid Ø Plak sarkoid Ø Skar sarkoid Ø Lupus pernio Ø Ülseratif sarkoid Ø Nadir varyantlar: Ø • Psoriasiform, Hypopigmented, Verrucous, folliculitis, Eruptive, Lichenoid, Erythrodermic, Cicatricial alopecia, Erythematous plaques of palms and soles, Nodular fingertip lesions, Unilateral lower extremity edema, granulomatous cheilitis, palmar erythema, morpheaform, angiolupoid, perforating, lupuserythematosus-like, umbilicated, rosacea-like syndrome.
Spesifik Deri Lezyonları: Makulopapular sarkoid Ø Noduler sarkoid Ø Plak sarkoid Ø Skar sarkoid Ø Lupus pernio Ø Ülseratif sarkoid Ø Nadir varyantlar: Ø • Psoriasiform, Hypopigmented, Verrucous, folliculitis, Eruptive, Lichenoid, Erythrodermic, Cicatricial alopecia, Erythematous plaques of palms and soles, Nodular fingertip lesions, Unilateral lower extremity edema, granulomatous cheilitis, palmar erythema, morpheaform, angiolupoid, perforating, lupuserythematosus-like, umbilicated, rosacea-like syndrome.
 Ø Dermatolojik muayenede diyaskopi ile papüler, plak ve nodüler lezyonlarda elma jölesi görünümü saptanır. Ø Sarkoidoz açısından önemli bir bulgudur, fakat spesifik değildir. Diğer granülomatöz hastalıklarda da bu bulgular görülebileceği için ayırıcı tanı için biopsi yapılarak tanı doğrulanmalıdır
Ø Dermatolojik muayenede diyaskopi ile papüler, plak ve nodüler lezyonlarda elma jölesi görünümü saptanır. Ø Sarkoidoz açısından önemli bir bulgudur, fakat spesifik değildir. Diğer granülomatöz hastalıklarda da bu bulgular görülebileceği için ayırıcı tanı için biopsi yapılarak tanı doğrulanmalıdır
 plak
plak
 Eritema nodozum
Eritema nodozum
 Eritema nodosum
Eritema nodosum

 Papüller multipl nodüller soliter
Papüller multipl nodüller soliter
 Anüler Sarkoidoz Ø Papüler lezyonlar birleşme eğilimi gösterebilirler veya anüler patern kazanabilirler. Ø Lezyonlar genellikle baş ve boyunda, özellikle alın, yanak ve ensede yerleşirler ve sıklıkla kronik sarkoidoz ile birliktedirler .
Anüler Sarkoidoz Ø Papüler lezyonlar birleşme eğilimi gösterebilirler veya anüler patern kazanabilirler. Ø Lezyonlar genellikle baş ve boyunda, özellikle alın, yanak ve ensede yerleşirler ve sıklıkla kronik sarkoidoz ile birliktedirler .
 Ø Anuler sarkoidoz
Ø Anuler sarkoidoz
 Lupus pernio; kronikleşme bulgusu
Lupus pernio; kronikleşme bulgusu
 Nasal nodül
Nasal nodül
 Lupus Pernio
Lupus Pernio
 Lupus pernio
Lupus pernio
 Lupus pernio
Lupus pernio


 Ø < TD>
Ø < TD>



 KARACİĞER-DALAK GRANÜLOMLARI
KARACİĞER-DALAK GRANÜLOMLARI
 ABDOMİNAL LAP
ABDOMİNAL LAP
 ELDE LİTİK LEZYONLAR
ELDE LİTİK LEZYONLAR



 GASTRİK SARKOİDOZ
GASTRİK SARKOİDOZ
 KOLONDA SARKOİDOZ
KOLONDA SARKOİDOZ
 NEFROKALSİNOZİS ve retroperitoneal lenf nodları
NEFROKALSİNOZİS ve retroperitoneal lenf nodları
 GÖZ Ø Konjunktivit, keratokonjunktivitis sikka, papilla ödemi, üveit Ø Vizyon bozukluğu, kuru göz, fotofobi Ø HEERFORDT SENDROMU: Üveit, parotid, fasiyal paralizi, ateş
GÖZ Ø Konjunktivit, keratokonjunktivitis sikka, papilla ödemi, üveit Ø Vizyon bozukluğu, kuru göz, fotofobi Ø HEERFORDT SENDROMU: Üveit, parotid, fasiyal paralizi, ateş
 Ø Göz Tutulumu : -Anterior veya posterior granulomatous uveitis -Konjunctival leziyon ve skleral plaques -Papilledema -Lakrimal gland (keratoconjuctivitis sicca)
Ø Göz Tutulumu : -Anterior veya posterior granulomatous uveitis -Konjunctival leziyon ve skleral plaques -Papilledema -Lakrimal gland (keratoconjuctivitis sicca)

 papilödem
papilödem
 Ø Nörolojik Tutulum : -Kranial sinir felci ve hypothalamic/pituitary disfonksiyon. -Lymphocytic meningitis
Ø Nörolojik Tutulum : -Kranial sinir felci ve hypothalamic/pituitary disfonksiyon. -Lymphocytic meningitis
 Ø 7. sinir: fasiyal paralizi Ø Optik sinir: papilla ödemi, görme bozuklukları Ø Periferik sinir: Parestezi, azalmış DTR(multipl sklerozla karışabilir)
Ø 7. sinir: fasiyal paralizi Ø Optik sinir: papilla ödemi, görme bozuklukları Ø Periferik sinir: Parestezi, azalmış DTR(multipl sklerozla karışabilir)
 AYIRICI TANI Ø Tüberküloz Ø Maligniteler Ø Aspergillozis Ø Kriptokokkozis Ø Histoplazmozis
AYIRICI TANI Ø Tüberküloz Ø Maligniteler Ø Aspergillozis Ø Kriptokokkozis Ø Histoplazmozis
 Prognoz • İyi: Erythema nodosum, akut inflammatuar bulgular (ateş, polyarthritis). • Kötü: Lupus pernio, kronik uveitis, yaş >40, kronik hypercalcemia, nephrocalcinosis, siyah ırk, nasal mucosal tutulum, kistik kemik lezyonları, neurosarcoidosis, myokardial tutulum.
Prognoz • İyi: Erythema nodosum, akut inflammatuar bulgular (ateş, polyarthritis). • Kötü: Lupus pernio, kronik uveitis, yaş >40, kronik hypercalcemia, nephrocalcinosis, siyah ırk, nasal mucosal tutulum, kistik kemik lezyonları, neurosarcoidosis, myokardial tutulum.
 Ø Temel Sarkoidozis Tanı Rehberi: • • • Hikaye/ CBC, BUN, Cr, LFTs, electrolytes, Ca. Urinalysis ACE seviyesi CXR PFTs (spirometry, volumes, diffusion measurements) Tüberkülin test with anergy panel. Ophthalmologic examination with both slit-lamp and fundus. Histoloji.
Ø Temel Sarkoidozis Tanı Rehberi: • • • Hikaye/ CBC, BUN, Cr, LFTs, electrolytes, Ca. Urinalysis ACE seviyesi CXR PFTs (spirometry, volumes, diffusion measurements) Tüberkülin test with anergy panel. Ophthalmologic examination with both slit-lamp and fundus. Histoloji.
 Ø TEDAVİ l 60% spontaneous rezolusyon(83% akut ). 1020% steroidle rezolusyon. Temel Amaç; fibrozisi önlemektir. • Steroid ilk tercih: • • Ağır cilt lezyonları Hiperkalsemi Ağır akciğer hastalığı Karaciğer tutulumu Kardiyak inflammation Posterior üveit Neurosarcoidosis Diğer organların ağır tutulumu
Ø TEDAVİ l 60% spontaneous rezolusyon(83% akut ). 1020% steroidle rezolusyon. Temel Amaç; fibrozisi önlemektir. • Steroid ilk tercih: • • Ağır cilt lezyonları Hiperkalsemi Ağır akciğer hastalığı Karaciğer tutulumu Kardiyak inflammation Posterior üveit Neurosarcoidosis Diğer organların ağır tutulumu
 Ø Tedavi Rehberi : • Sistemik Sarkoidozis: • Prednisone 1 mg/kg/d x 4 -6 weeks followed by a slow taper over 2 -3 months. • Hydroxychloroquine 2 -3 mg/kg/day x 12 weeks (30 -50% success). • MTX 15 mg/week in 3 divided doses at 12 hour intervals x 9 -11 months (94% success). • Thalidomide (TNF blocker) • Infliximab (Ab against TNF-ά); Etanercept (receptor for TNF).
Ø Tedavi Rehberi : • Sistemik Sarkoidozis: • Prednisone 1 mg/kg/d x 4 -6 weeks followed by a slow taper over 2 -3 months. • Hydroxychloroquine 2 -3 mg/kg/day x 12 weeks (30 -50% success). • MTX 15 mg/week in 3 divided doses at 12 hour intervals x 9 -11 months (94% success). • Thalidomide (TNF blocker) • Infliximab (Ab against TNF-ά); Etanercept (receptor for TNF).
 Ø Ø Ø Ø KAYNAKLAR 1. American Thoracic Society (ATS), European Respiratory Society (ERS), and World Association of Sarcoidosis and Other Granulomatous Disorders (WASOG). Statement on sarcoidosis. Am J Respir Crit Care Med. 1999; 160: 736 -755. 2. Israel HL, Gottlieb JE, Peters SP. The importance of ethnicity in the diagnosis and prognosis of sarcoidosis. Chest 1997; 111: 838 -840. 3. Fanburg BL, Villa O. Sarcoidosis. Murray JF and Nadel JA edit. Textbook of Respiratory Medicine. Philadelphia, W. B. Saunders Company, 2000; 1717 -1732. 4. Quernheim JM. Sarcoidosis: İmmunopathogenetic concepts and their clinical application. Eur Respir J, 1998; 12: 716 -738. 5. White ES, Lynch JP. Sarcoidosis involving multiple systems. Diagnostic and therapeutic challenges. Chest 200 l; 119: 1593 -1597. 6. Mana J, Gomez-Vaquero C, Montero A, et al. Löfgren's Syndrome revisited: A study of 186 patients. Am J Med. 1999; 107: 240 -245. 7. Yanardağ H. Sarkoidozda kalp tutulumu. Hipokrat Kardiyoloji Derg. 2003 ; 23(4)121 -124. 8. Newman LS, Rose CS, Maier LA. Sarcoidosis. N Eng J Med. 1997; 336: 1224 -1234. 9. Tambouret R, Geisinger KR, Powers CN, et al. The clinical application and cost analysis of fineneedle aspiration biopsy in the diagnosis of mass lesions in sarcoidosis. Chest 2000; 117: 931 -932. 10. Newman LS, Rose CS. Sarcoidosis. Fishman AP, editör. Fishman’s Pulmonary Diseases and Disorders. New York, Mc. Graw. Hill, 1998; 1841 -1849. 11. Uygun S, Yanardag H, Karter Y, Demirci S. Course and prognosis of sarcoidosis in a referral setting in Turkey; analysis of 166 patients. Acta Medica (Hradec Kralove). 2006; 49(1): 51 -7. 12. Judson MA. An approach to the treatment of pulmonary sarcoidosis with corticosteroids: the six phases of treatment. Chest 1999; 115: 1158 -1165. 13. Yanardağ H, Pamuk ON, Karayel T. Cutaneous involvement in sarcoidosis: analysis of the features in 170 patients. Respir Med. 2003 Aug; 97(8): 978 -82. 14 Baughman RP, Ohmichi M, Lower EE. Combination therapy for sarcoidosis. Sarcoidosis Vasc Diffuse Lung Dis 2001; 18: 133137.
Ø Ø Ø Ø KAYNAKLAR 1. American Thoracic Society (ATS), European Respiratory Society (ERS), and World Association of Sarcoidosis and Other Granulomatous Disorders (WASOG). Statement on sarcoidosis. Am J Respir Crit Care Med. 1999; 160: 736 -755. 2. Israel HL, Gottlieb JE, Peters SP. The importance of ethnicity in the diagnosis and prognosis of sarcoidosis. Chest 1997; 111: 838 -840. 3. Fanburg BL, Villa O. Sarcoidosis. Murray JF and Nadel JA edit. Textbook of Respiratory Medicine. Philadelphia, W. B. Saunders Company, 2000; 1717 -1732. 4. Quernheim JM. Sarcoidosis: İmmunopathogenetic concepts and their clinical application. Eur Respir J, 1998; 12: 716 -738. 5. White ES, Lynch JP. Sarcoidosis involving multiple systems. Diagnostic and therapeutic challenges. Chest 200 l; 119: 1593 -1597. 6. Mana J, Gomez-Vaquero C, Montero A, et al. Löfgren's Syndrome revisited: A study of 186 patients. Am J Med. 1999; 107: 240 -245. 7. Yanardağ H. Sarkoidozda kalp tutulumu. Hipokrat Kardiyoloji Derg. 2003 ; 23(4)121 -124. 8. Newman LS, Rose CS, Maier LA. Sarcoidosis. N Eng J Med. 1997; 336: 1224 -1234. 9. Tambouret R, Geisinger KR, Powers CN, et al. The clinical application and cost analysis of fineneedle aspiration biopsy in the diagnosis of mass lesions in sarcoidosis. Chest 2000; 117: 931 -932. 10. Newman LS, Rose CS. Sarcoidosis. Fishman AP, editör. Fishman’s Pulmonary Diseases and Disorders. New York, Mc. Graw. Hill, 1998; 1841 -1849. 11. Uygun S, Yanardag H, Karter Y, Demirci S. Course and prognosis of sarcoidosis in a referral setting in Turkey; analysis of 166 patients. Acta Medica (Hradec Kralove). 2006; 49(1): 51 -7. 12. Judson MA. An approach to the treatment of pulmonary sarcoidosis with corticosteroids: the six phases of treatment. Chest 1999; 115: 1158 -1165. 13. Yanardağ H, Pamuk ON, Karayel T. Cutaneous involvement in sarcoidosis: analysis of the features in 170 patients. Respir Med. 2003 Aug; 97(8): 978 -82. 14 Baughman RP, Ohmichi M, Lower EE. Combination therapy for sarcoidosis. Sarcoidosis Vasc Diffuse Lung Dis 2001; 18: 133137.


